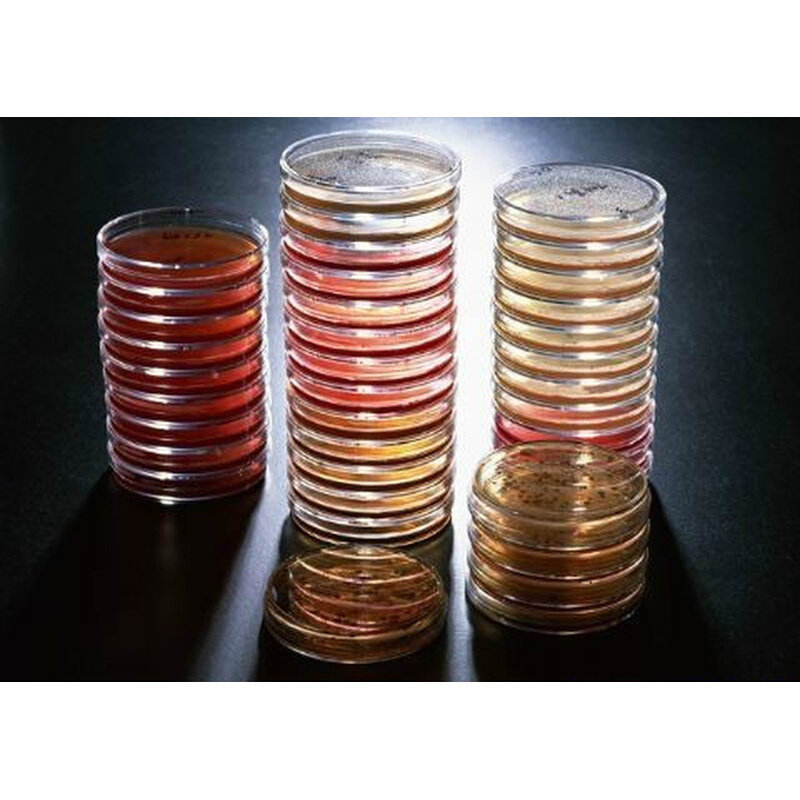
北京陆桥 pb036 麦康凯琼脂平板 90.00  10 皿/ 包&times;2
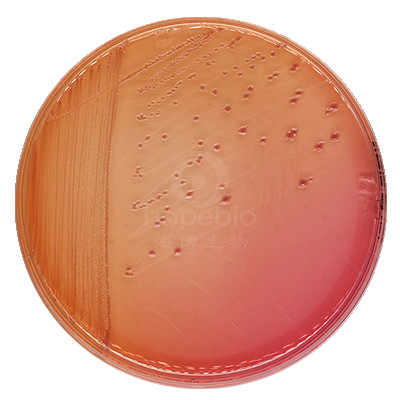
麦康凯琼脂平板(9cm) hbpm016 10个/包 青岛海博生物

麦康凯平板

北京陆桥 pb036 麦康凯琼脂平板 90.00 10 皿/ 包×2
图片尺寸800x800
麦康凯平板的使用 用于大肠,沙门,志贺的分离,多用于肠道杆菌的培养.
图片尺寸1282x1280
麦康凯琼脂培养基平板无菌平皿 即用型培养基平板 90mm 10皿/包
图片尺寸2864x2864
麦康凯琼脂培养基平板macc无菌平皿 即用型培养基平板 10皿/包 φ90mm
图片尺寸800x800
麦康凯琼脂平板(9cm) hbpm016 10个/包 青岛海博生物
图片尺寸400x400
玫瑰红钠琼脂培养基 - 平板,麦康凯琼脂培养基 - 平板
图片尺寸741x513
改良麦康凯琼脂平板用于o157菌的选择性分离培养9cm*10个/包
图片尺寸800x800
来源:图1:分离自尿液的大肠埃希菌(麦康凯平板)图2:分离自腹水的大肠
图片尺寸1080x1439
麦康凯琼脂培养基平板 7cm9cm70mm90mm哥伦比亚血琼脂平板 哥伦比亚血
图片尺寸800x800
云程营养琼脂平皿/麦康凯/ 即用型培养基 无菌培养基平板 na平皿 10皿
图片尺寸800x800
营养琼脂平皿/麦康凯/ 即用型培养基 无菌培养基平板 na平皿 10皿
图片尺寸800x800
麦康凯琼脂培养基平板macc平皿 即用型培养基平板 10皿/包
图片尺寸800x800
营养琼脂平板 水产孤菌tcbs平皿 麦康凯 血琼脂 r2a lb mh琼脂 大豆酪
图片尺寸800x800
麦康凯琼脂平板
图片尺寸500x484
麦康凯平板的使用 用于大肠,沙门,志贺的分离,多用于肠道杆菌的培养.
图片尺寸1599x1280
麦康凯琼脂培养基平板 7cm9cm70mm90mm哥伦比亚血琼脂平板实验室
图片尺寸800x800
麦康凯琼脂平板(9cm) hbpm016 10个/包 青岛海博生物
图片尺寸400x400
蛋白胨卵磷脂吐温80乳糖发酵 lb肉汤月桂基硫结晶紫中性红胆盐麦康凯
图片尺寸800x800
麦康凯琼脂平板(含结晶紫)9cm*10 无菌固体培养基 芜湖欧克生物
图片尺寸800x800
麦康凯平板的使用 用于大肠,沙门,志贺的分离,多用于肠道杆菌的培养.
图片尺寸1527x1280